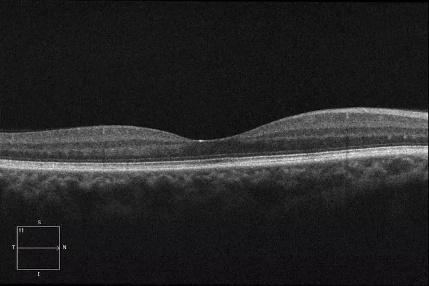
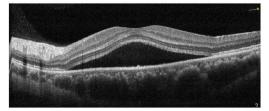

青浦卫健说丨中奖了?不!是“中浆”——中心性浆液性脉络膜视网膜病变
你得了“中浆”


啥?我中奖了?
在日常生活中,我们常常听到“中奖”这样的词汇,它代表着幸运和喜悦。然而,今天我们要聊的却是一个与“中奖”谐音,却截然不同的健康话题——“中浆”,全称为中心性浆液性脉络膜视网膜病变。“中浆”是一种由于脉络膜血管通透性增强,继发视网膜色素上皮屏障功能受损所导致的局限性视网膜神经上皮脱离的眼底疾病。
正常黄斑区的OCT影像
“中浆”的OCT影像
“中浆”好发于25-45岁的中青年,男性的发病率高于女性,特别是A型性格的人更容易患“中浆”。

得了“中浆”会有什么症状
01
视力下降:
患者会感觉到单眼或双眼的视力逐渐模糊,视力下降。
02
视物变形:
看东西时,物体的形状会发生变化,如变直为曲、变小等。
03
中心暗点:
视野中心区域会出现暗点,影响视觉清晰度。
04
色觉改变:
部分患者还会出现色觉异常,如颜色变暗等。

正常视力

视物模糊

中心暗点

色觉异常
“中浆”的诱发因素
01
精神紧张:
长期的精神压力是“中浆”的重要诱因。
02
高血压:
高血压患者更易发生眼底血管病变。
03
系统性红斑狼疮、器官移植、
激素的使用和妊娠::
这些因素也可能增加“中浆”的发病风险。
“中浆”的治疗
本病多数患者急性发病后4-6个月可自行好转,视力可恢复正常;但部分患者视物变形、色觉异常等视功能改变可持续存在;少数患者病程可迁延持续6月以上,甚至转为慢性。首次发病后,约30%-50%再次复发。
中药、针灸等中医治疗对中浆具有显著疗效。中医多以局部辨证与全身辨证相结合,局部辨证是水肿期加渗湿利水苭,渗出为主者加活血祛瘀或化痰软坚药物。针灸疗法通过在特定穴位施以细针刺激来调节气血、平肝潜阳,多选取瞳子髎、攒竹、睛明、合谷、足三里等穴位,改善局部血液循环、缓解眼部不适。
视网膜光凝或微脉冲激光可通过激光光凝封闭渗漏点或促进渗漏点周围视网膜修复,促进神经上皮下积液吸收。
此外,需要特别注意的是,“中浆”患者禁用激素,使用激素可能会发生大泡性视网膜脱离,加重病情。
如何预防“中浆”
01
保持心情愉悦:
避免长期精神紧张和压力过大。
02
健康生活方式:
戒烟限酒、合理饮食、适量运动,保持身体健康。
03
定期体检:
特别是对于有高血压等慢性疾病的人群,应定期进行眼底检查。
“中浆”不是“中奖”,但当我们面对生活中的“中浆”时,也应保持积极乐观的心态,及时就医并采取有效的治疗措施。同时,也要注意预防疾病的发生,保护好自己的视力健康。健康才是人生最大的财富!
原标题:《青浦卫健说丨中奖了?不!是“中浆”——中心性浆液性脉络膜视网膜病变》

